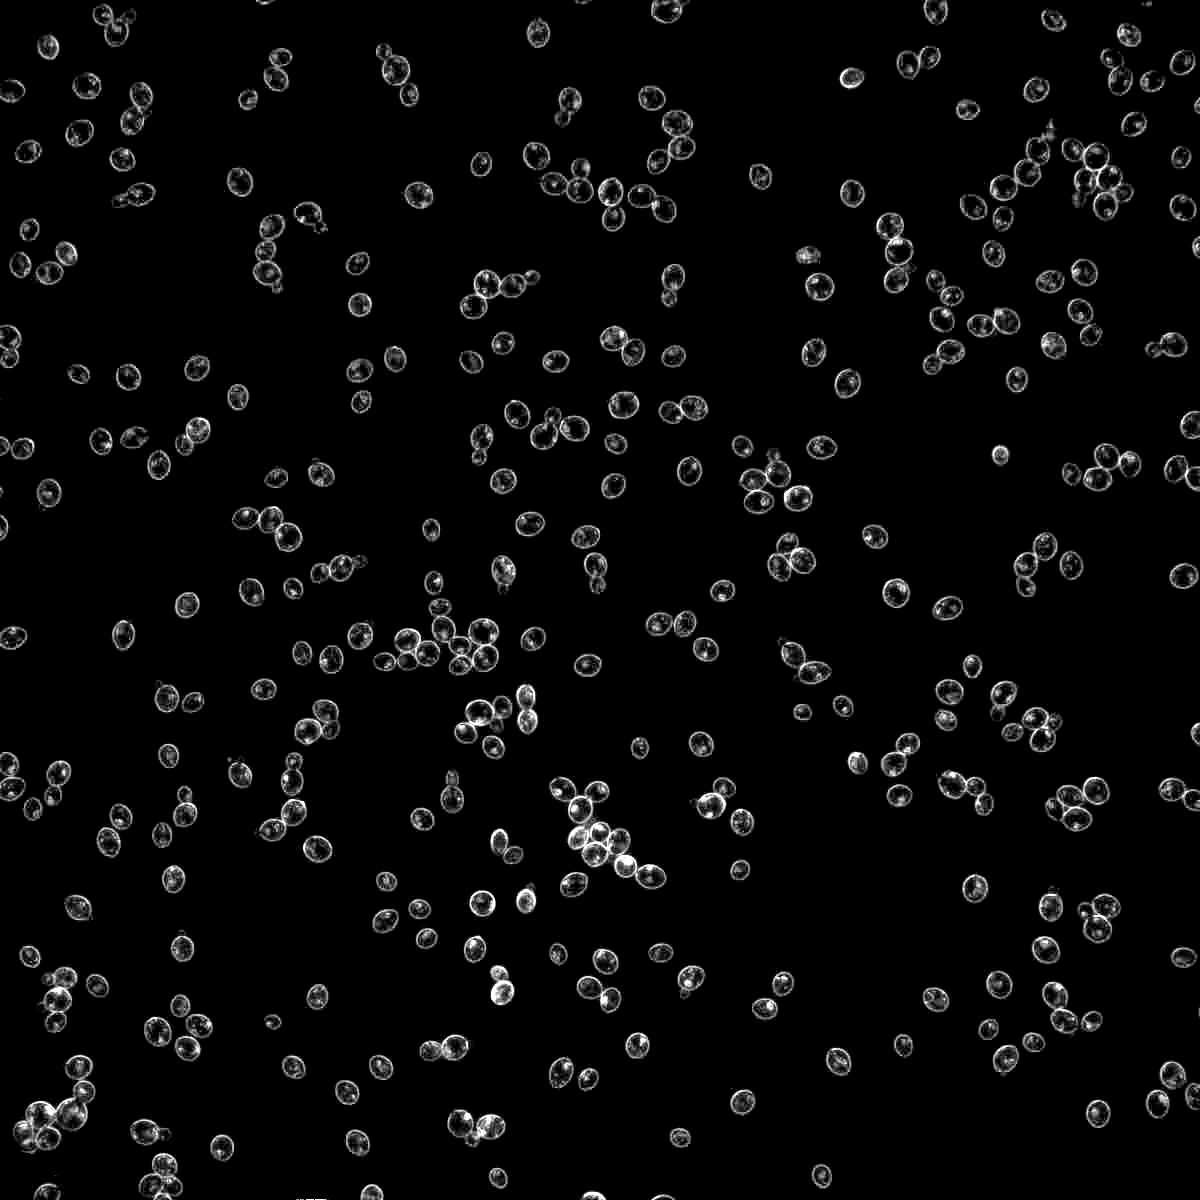
1084

2633

Baltic Porter
BJCP 9C
Strong European Lager
Overall Impression:
Aldaris Porteris, Baltika #6 Porter, Devils Backbone Danzig, Okocim Porter, Sinebrychoff Porter, Zywiec Porter
A Baltic Porter often has the malt flavors reminiscent of an English porter and the restrained roast of a schwarzbier, but with a higher OG and alcohol content than either. Very complex, with multi-layered malt and dark fruit flavors.
Commercial Examples:Aldaris Porteris, Baltika #6 Porter, Devils Backbone Danzig, Okocim Porter, Sinebrychoff Porter, Zywiec Porter
*The Style Name, Overall Impression, and Commercial Examples are borrowed with permission from the BJCP.
Scroll down